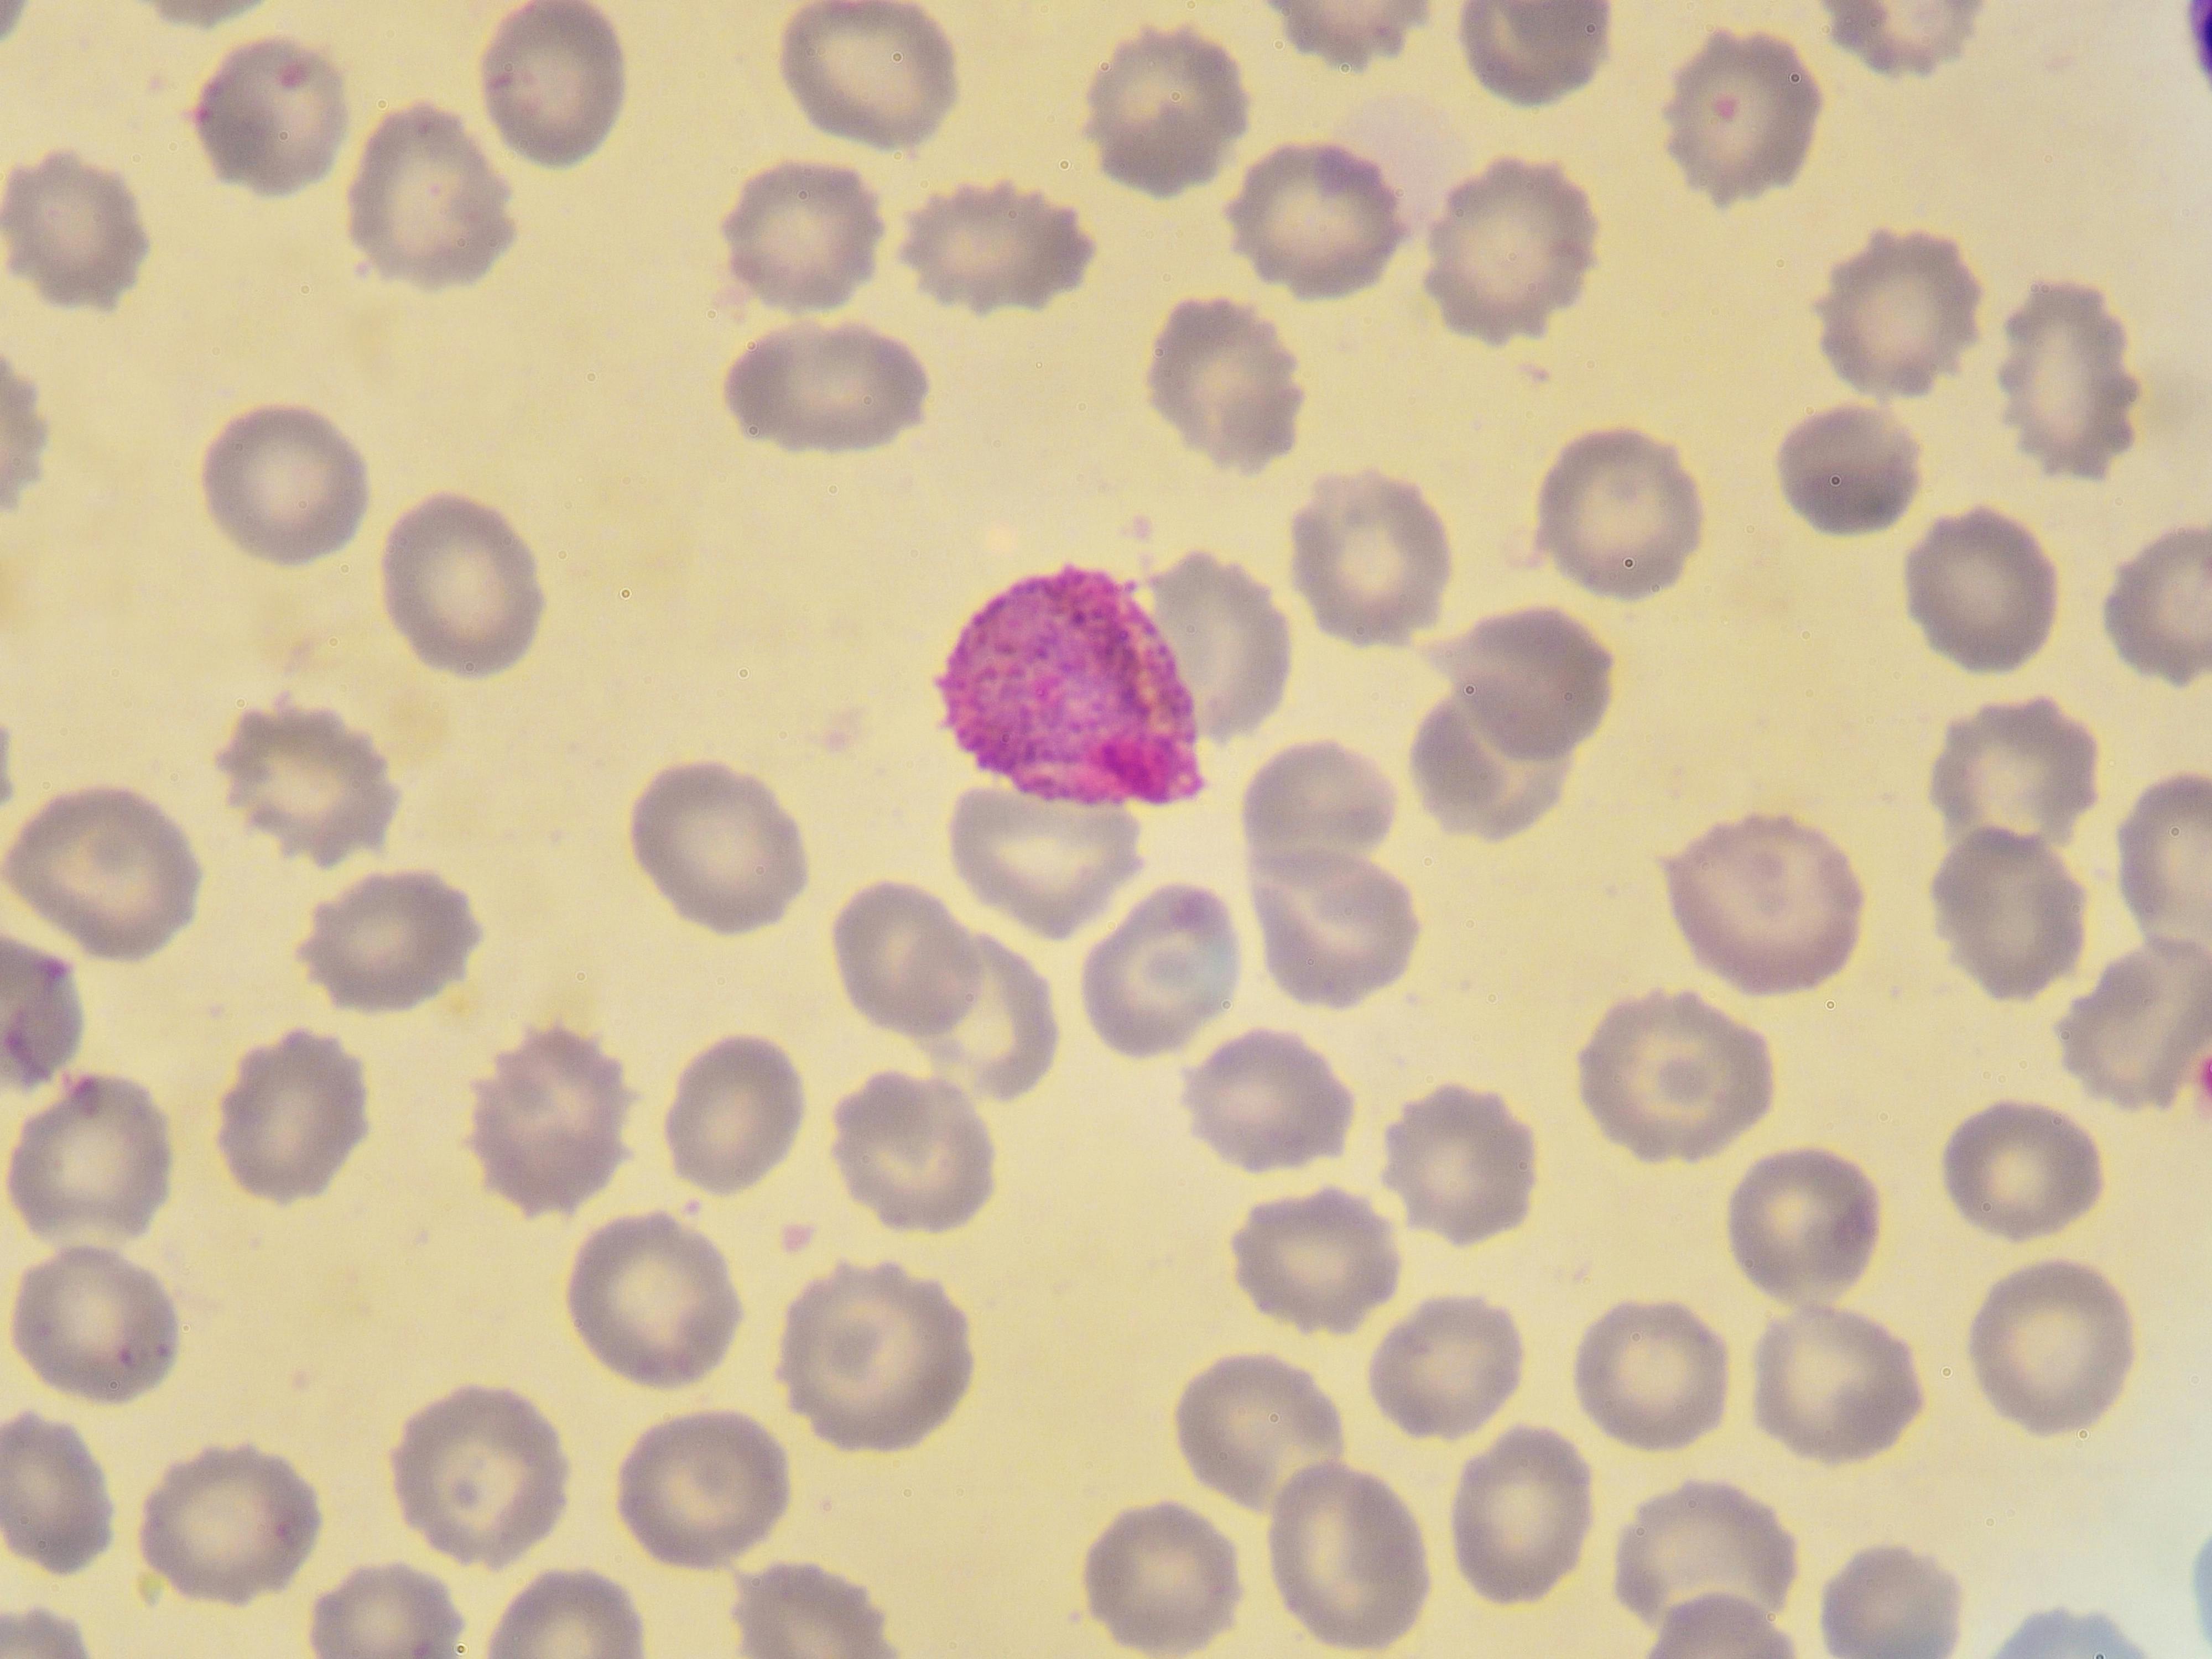
675b0132dcbe049b87b0e085 Dreamstime Xxl 99829496
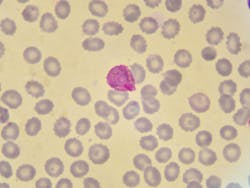
675b0132dcbe049b87b0e085 Dreamstime Xxl 99829496 675b0132dcbe049b87b0e085 Dreamstime Xxl 99829496

The World Health Organization (WHO) published new data in the latest World malaria report, revealing the disease remains a serious global health threat.
According to the report, “there were an estimated 263 million cases and 597,000 malaria deaths worldwide in 2023. This represents about 11 million more cases in 2023 compared to 2022, and nearly the same number of deaths. Approximately 95% of the deaths occurred in the WHO African Region, where many at risk still lack access to the services they need to prevent, detect and treat the disease.”
Additionally, “as of November 2024, 44 countries and 1 territory had been certified malaria-free by WHO, and many more are steadily progressing towards the goal. Of the 83 malaria-endemic countries, 25 countries now report fewer than 10 cases of malaria a year, an increase from 4 countries in 2000.”
The WHO African Region achieved a 16% reduction in malaria deaths since 2015. WHO calls for accelerated progress to reach the target level of 23 deaths per 100,000 population.
Additional data from WHO:
· As of December 2024, 17 countries had introduced malaria vaccines through routine childhood immunization.
· New-generation nets, which provide better protection against malaria than pyrethroid-only nets, are becoming more widely available, supporting efforts to combat mosquito resistance to pyrethroids. In 2023, these new types of nets accounted for 78% of the 195 million nets delivered to sub-Saharan Africa, an increase from 59% in 2022.
· Funding for malaria control globally remains inadequate to reverse current trends, especially in high-burden African countries. In 2023, total funding reached an estimated US$ 4 billion, falling far short of the year’s funding target of US$ 8.3 billion set by the Global technical strategy. Insufficient funding has led to major gaps in coverage of insecticide-treated nets, medicines, and other life-saving tools, particularly for those most vulnerable to the disease.